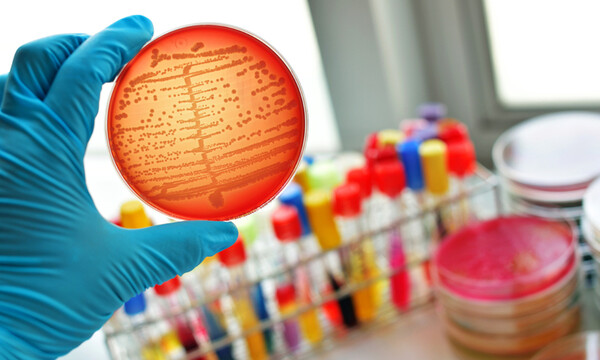
Σηψαιμία: 11 επικίνδυνα συμπτώματα σε εικόνες

Onmed.gr

ΠΕΡΙΕΡΓΑ
18 Ιουλίου 2019, 10:30
Υγεία κόλπου: Συμπτώματα που χρήζουν επείγουσας αντιμετώπισης (εικόνες)
Υγεία κόλπου: Συμπτώματα που χρήζουν επείγουσας αντιμετώπισης (εικόνες)
Οι δυσάρεστες οσμές στην ευαίσθητη περιοχή είναι κάτι που οι…

ΠΕΡΙΕΡΓΑ
17 Ιουλίου 2019, 10:30
Ροδάκινο: Θερμίδες και οφέλη για την υγεία (εικόνες)
Ροδάκινο: Θερμίδες και οφέλη για την υγεία (εικόνες)
Το ροδάκινο αποτελεί το ιδανικό καλοκαιρινό σνακ. Έχει μόλις 37…

ΠΕΡΙΕΡΓΑ
16 Ιουλίου 2019, 21:00
Αυξημένη κρεατινίνη: 6 τρόποι για να την μειώσετε (εικόνες)
Αυξημένη κρεατινίνη: 6 τρόποι για να την μειώσετε (εικόνες)
Η κρεατινίνη είναι ένα φυσιολογικό, αλκαλικό συστατικό του αίματος και…

ΠΕΡΙΕΡΓΑ
16 Ιουλίου 2019, 10:40
Συγκέντρωση, μνήμη, παραγωγικότητα: 10 τροφές για να τις ενισχύσετε (εικόνες)
Συγκέντρωση, μνήμη, παραγωγικότητα: 10 τροφές για να τις ενισχύσετε (εικόνες)
Ο πρωινός καφές μπορεί να σας δίνει τη δόση ενέργειας…

ΠΕΡΙΕΡΓΑ
15 Ιουλίου 2019, 21:00
Αίμα στα ούρα: 7 πιθανές αιτίες σε εικόνες
Αίμα στα ούρα: 7 πιθανές αιτίες σε εικόνες
Το αίμα στα ούρα ή η αιματουρία μπορεί να αποτελεί ένδειξη…

ΠΕΡΙΕΡΓΑ
15 Ιουλίου 2019, 10:30
Τροφές με πολλές θερμίδες που αδυνατίζουν (εικόνες)
Τροφές με πολλές θερμίδες που αδυνατίζουν (εικόνες)
Για να χάσετε βάρος, δεν αρκεί μόνο να μειώσετε τις…

ΠΕΡΙΕΡΓΑ
14 Ιουλίου 2019, 21:09
Κράμπες περιόδου: Πώς θα τις αντιμετωπίσετε (εικόνες)
Κράμπες περιόδου: Πώς θα τις αντιμετωπίσετε (εικόνες)
Οι κράμπες κατά τη διάρκεια της περιόδου προκαλούνται από τις…

ΠΕΡΙΕΡΓΑ
14 Ιουλίου 2019, 12:00
Τα βότανα που αυξάνουν τη θρεπτική αξία των φαγητών (εικόνες)
Τα βότανα που αυξάνουν τη θρεπτική αξία των φαγητών (εικόνες)
Τα βότανα xαρίζουν γεύση στα πιάτα, ενισχύοντας παράλληλα τη διατροφική…

ΠΕΡΙΕΡΓΑ
13 Ιουλίου 2019, 20:55
Πόνος στην πλάτη: Έτσι θα τον αντιμετωπίσετε (εικόνες)
Πόνος στην πλάτη: Έτσι θα τον αντιμετωπίσετε (εικόνες)
Ο πόνος στην πλάτη αποτελεί «μάστιγα» λόγω του σύγχρονου τρόπου…

ΠΕΡΙΕΡΓΑ
13 Ιουλίου 2019, 10:30
Υψηλό σάκχαρο στο αίμα: Έξι συμπτώματα που πρέπει να προσέξετε (εικόνες)
Υψηλό σάκχαρο στο αίμα: Έξι συμπτώματα που πρέπει να προσέξετε (εικόνες)
Το υψηλό σάκχαρο στο αίμα μπορεί να εμφανιστεί ακόμα και…

ΠΕΡΙΕΡΓΑ
12 Ιουλίου 2019, 21:00
Κολπική φαγούρα: 9 λόγοι που την προκαλούν (εικόνες)
Κολπική φαγούρα: 9 λόγοι που την προκαλούν (εικόνες)
H φαγούρα στον κόλπο είναι μια άβολη και συχνά επώδυνη…

ΠΕΡΙΕΡΓΑ
12 Ιουλίου 2019, 10:30
4 είδη πονοκεφάλου & πώς αντιμετωπίζονται (εικόνες)
4 είδη πονοκεφάλου & πώς αντιμετωπίζονται (εικόνες)
Ο πονοκέφαλος είναι ο πιο κοινός πόνος και ο συνηθέστερος…

ΠΕΡΙΕΡΓΑ
11 Ιουλίου 2019, 21:00
Μούδιασμα στα χέρια: 18 πιθανές αιτίες (εικόνες)
Μούδιασμα στα χέρια: 18 πιθανές αιτίες (εικόνες)
Το μούδιασμα στα χέρια είναι μια κατάσταση που συνήθως προκαλείται…

ΠΕΡΙΕΡΓΑ
11 Ιουλίου 2019, 10:37
Τα θρεπτικά συστατικά που βελτιώνουν τον ύπνο & από πού θα τα λάβετε (εικόνες)
Τα θρεπτικά συστατικά που βελτιώνουν τον ύπνο & από πού θα τα λάβετε (εικόνες)
Δυσκολεύεστε να κοιμηθείτε ή υποφέρετε από αϋπνίες;
ΠΕΡΙΕΡΓΑ
10 Ιουλίου 2019, 21:00
Σηψαιμία: 11 επικίνδυνα συμπτώματα σε εικόνες
Σηψαιμία: 11 επικίνδυνα συμπτώματα σε εικόνες
Η σηψαιμία είναι μια σοβαρή επιπλοκή λοίμωξης, η οποία συμβαίνει…









